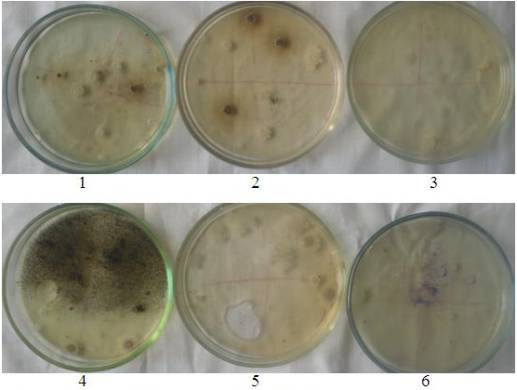

К.с.-х. Захаров В.Л, Коновалова Н.И.
Мичуринский филиал
Российского университета кооперации, Россия
Антимикробные
свойства плодов рябины и аронии
в
пшеничном хлебе
Плоды рябины содержат более 2% кислот [5],
в том числе и сорбиновую, отличающуюся особенно бактерицидной активностью.
Целью данной работы было выяснить влияние измельчённых плодов рябины (сорт
Сорбинка и Рубиновая) и аронии черноплодной в количестве 6,8 % на количество
микроорганизмов в пшеничном хлебе. Плоды предварительно были высушены естественным
образом в проветриваемом помещении при размещении их тонким слоем. Влажность их
составляла 30 %. Затем плоды пропускались через мясорубку и замешивались в
тесто из расчёта 6,8 г добавки на 100 г изделия. Для сравнения с рябиной и
аронией аналогичным образом использовали плоды шиповника. В смешанном варианте
добавляли 3,4 г шиповника и 3,4 г аронии. Хлеб пшеничный из муки высшего сорта
выпекали 5.03.2013 г. Масса готовых изделий составляла в среднем 100 г. После
выпечки хлеба были отобраны образцы по ГОСТ 5667 [1]. Через 2 дня после выпечки
хлеба проводили микробиологические анализы. Исходное разведение (1:10)
готовилось путём растворения 10 г хлеба в 90 мл стерильной водопроводной воды
до гомогенной массы. Общую бактериальную обсеменённость (КМАФАнМ) определяли
посевом на питательный агар [3], а общее число дрожжей и плесневых грибов – на
агар Сабуро [2]. По сравнению с контролем (без добавок) добавки из плодов используемых
культур обеспечили снижение количества микроорганизмов в хлебе (рис.). В 1 мг
хлеба с шиповником отмечено в 55 раз меньше колониальных единиц (КОЕ) бактерий
и в 3 раза меньше дрожжей и грибов, чем в контрольном образце, что объясняется
большим количеством аскорбиновой кислоты и Р-активных веществ, подавляющих рост
и развитие микроорганизмов. Ещё больший
антимикробный эффект обеспечила рябина и арония.
Рис.
1. Колонии микроорганизмов на 4 сутки после посева (разведение 1:10): бактерии
на питательном агаре на после посева хлеба с шиповником (1), со смесью
шиповника с аронией (2) и с аронией (3); дрожжи и плесневые грибы на агаре
Сабуро после посева хлеба без добавок (4), с шиповником (5) и с аронией (6).
Наименьшее количество бактерий отмечено в
хлебе с плодами рябины сорта Сорбинка (снижение в 290 раз), а дрожжей и
плесеней – в варианте с аронией (снижение в 14 раз) (табл.).
Таблица 1. Содержание микроорганизмов в хлебе
пшеничном с добавкой рябины, аронии и шиповника
|
Показатель, КОЕ/мг |
Контроль |
Шиповник |
Сорбинка |
Рубиновая |
Шиповник+ арония |
Арония |
|
КМАФАнМ |
293567 |
5333 |
1010 |
1500 |
1017 |
1930 |
|
Общее число дрожжей и
плесневых грибов |
9000 |
3000 |
813 |
1250 |
3133 |
610 |
Примечание: КМАФАнМ – количество мезофильных аэробных
и факультативно-анаэробных микроорганизмов (общая бактериальная
обсеменённость).
Согласно единым
санитарно-эпидемиологическим и гигиеническим требованиям общая бактериальная
обсеменённость свежеиспечённого хлеба должна быть не более 1000 КОЕ/г, а
количество плесеней – не более 50 КОЕ/г [4]. Через 2 дня количество бактерий в
варианте с Сорбинкой было почти в пределах нормы, которая Сорбиновая кислота
рябины замедляет развитие плесеней: контрольный хлеб, а также с добавкой
шиповника начал плесневеть на 8-й день, а с добавками рябины и аронии – на
12-й.
Таким образом, добавка плодов рябины сорта
Сорбинка максимально снижает численность бактерий, а аронии – дрожжей и
плесневых грибов.
Литература:
1. ГОСТ 5667-65. Хлеб и хлебобулочные
изделия. Правила приёмки, методы отбора образцов, методы определения
органолептических показателей и массы изделий. Утверждён и введён в действие
Государственным Комитетом стандартов, мер и измерительных приборов СССР
28.05.1965г. – 4с.
2. ГОСТ 10444.12-88. Продукты пищевые.
Метод определения дрожжей и плесневых грибов. Утверждён и введён в действие
Постановлением Государственного Комитета СССР по стандартам № 3208 от 21.09.88
г. – 7 с.
3. ГОСТ 10444.15-94. Продукты пищевые.
Методы определения количества мезофильных аэробных и факультативно-анаэробных
микроорганизмов. Введён в действие Постановлением Комитета РФ по
стандартизации, метрологии и сертификации 1.01.1996 г. № 77. – 7 с.
4. Единые санитарно-эпидемиологические
требования к товарам, подлежащим санитарно-эпидемиологическому надзору
(контролю). Утверждены Решением Комиссии Таможенного союза от 28.05.2010 г. №
299.
5. Фёдоров Ф.В. Дикорастущие пищевые
растения / Изд. 2-е, перераб. и доп. – Чебоксары: Чуваш кн. изд-во, 1993. – 215
с.